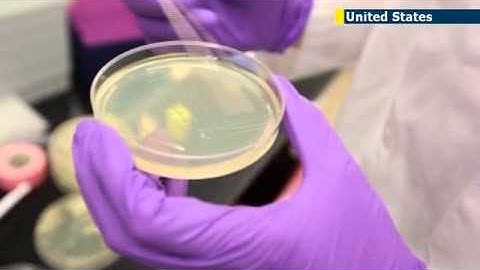
Scientists move step closer to creating artificial life with creation of artificial yeast chromosome

⬇ DOWNLOAD NOW
Kalau muncul iklan pop-up, tutup lalu klik tombol kembali
Download lagu Chinese scientists create world’s first functional single-chromosome yeast secara gratis hanya untuk keperluan promosi. Dukung artis favorit kamu dengan membeli musik original di iTunes atau platform resmi lainnya.
 Scientists Synthesize First Functional "Designer" Chromosome in Yeast
Scientists Synthesize First Functional "Designer" Chromosome in Yeast
 Scientists have synthesized yeast chromosomes
Scientists have synthesized yeast chromosomes
Scientists move step closer to creating artificial life with creation of artificial yeast chromosome
Scientists move step closer to creating artificial life with creation of artificial yeast chromosome
 Work begins to create artificial human DNA from scratch | BBC News
Work begins to create artificial human DNA from scratch | BBC News
 Scientists Build a Custom Chromosome
Scientists Build a Custom Chromosome
 Scientists Create Embryos from Human SKIN Cells
Scientists Create Embryos from Human SKIN Cells
 Doctor Explains World First Genetics
Doctor Explains World First Genetics
 Scientists Build DNA From Scratch Using Yeast
Scientists Build DNA From Scratch Using Yeast